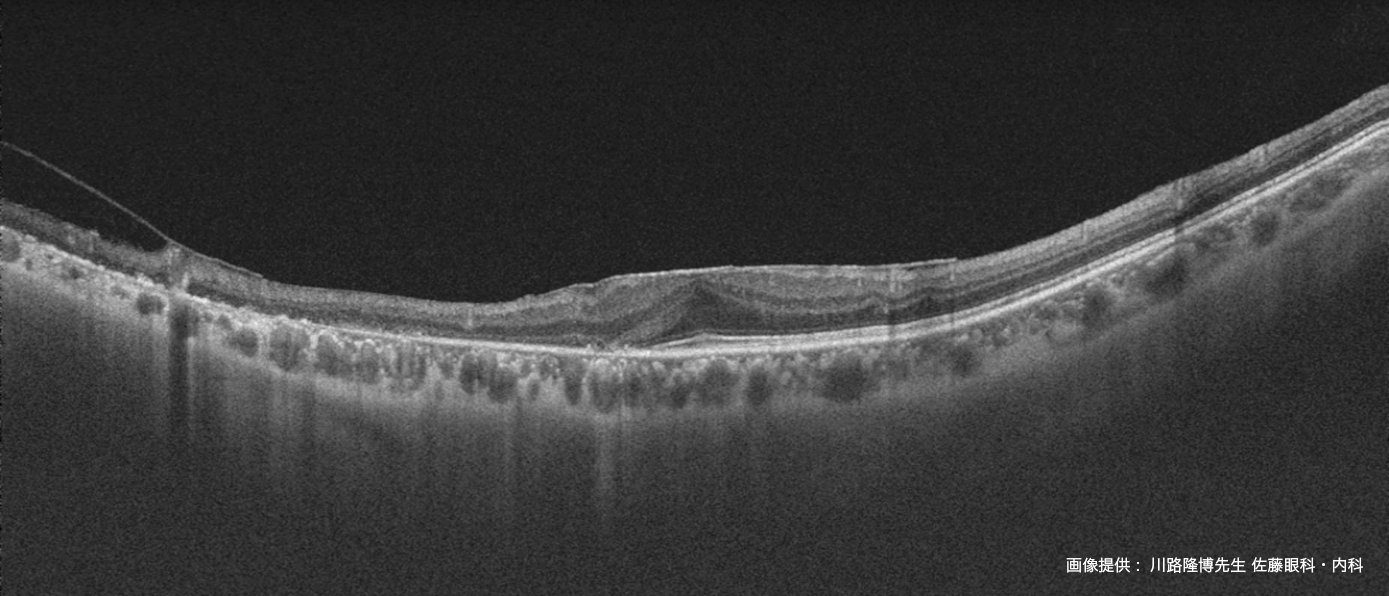

- 診断機器
- 3次元眼底像撮影装置
Triton2
Swept-Source OCTと高画質眼底カメラの組み合わせは、診断精度の向上、
臨床ワークフローの効率化、そして被検者のケアの質の向上に貢献します。
信頼性の高いSwept-Source OCTは12mmの広範囲撮影において
デノイズ効果を発揮し、さらに見やすい画像を提供します。
加えて、広角撮影や前眼部撮影にも対応。機器間の移動は不要で、
簡単な操作で迅速に追加検査を行うことができます。

主な特徴
- マルチモダルイメージング
診断に有用な撮影機能を集約 - 白内障や硝子体混濁のある疾患眼に対しても鮮明なOCT 像を表示
- 高画質高精細
Swept Source OCT - 広角OCT/OCT-Angiography
かんたん広角撮影 - Smart Denoise
BスキャンおよびOCT-A画像を
鮮明に描写 - 新しいIMAGEnet®7
洗練されたUIと操作性 - 豊富な解析レポート
DEEP RANGE SS OCT × HIGH QUALITY FUNDUS IMAGING

明るい検査室でも、簡単な操作で様々な被検者に対し、OCTと眼底画像を一度に撮影できるTriton2 & IMAGEnet®7は、
日々の臨床の質向上と効率化を支援します。

暗室はもちろん、明室でもシャープで自然な色味の眼底画像を提供します。スリット照明とローリングシャッター機構により、
フレアや影を少なくし、高画質のカラー眼底画像を取得することが可能です。低画質の要因の一つである小瞳孔において、
スリットスキャン機構は撮り直しが少なく、コントラストの高い画像を撮影することができます。
この技術は、従来機とは異なり、瞳孔縮小や照明条件に関係なく、シャープで高画質な眼底画像の撮影に可能にします。

画像のご提供: Adjunct A/Prof. Kelvin Teo, M.D., Ph.D. Senior Consultant Ophthalmologist at Advanced Eye Clinic and Surgery
DRI OCT Triton シリーズにトプコン独自のアルゴリズムOCT Angiography Ratio Analysis = OCTARA™を搭載したことで、
脈絡膜レベルの血流まで高感度、高侵達に画像化します¹。トプコン独自のアルゴリズムOCTARA は、
同じ断面で撮影された複数のOCT 画像から血管内の血流の様子を画像化する技術です。弱い信号変化でも高感度で画像化できるため、
毛細血管の観察など臨床に活用されています。

広範囲の OCT および OCT-A 撮影によって、多彩な検査ルーチンに対応できます。

本体の側面からも操作が行えます。
本体モニターを動かすことで、
患者さんの開瞼も容易に行えるので
撮影がスムーズに完了します。
販売名:3 次元眼底像撮影装置 DRI OCT Triton2
医療機器届出番号:307AABZX00054000
販売名:眼科データ管理システム IMAGEnet 7
医療機器届出番号:307AABZX00051000
1 Charles Reisman, MS; Atsushi Kubota, MS; Masahiro Akiba, PhD; Catharine Chisholm, PhD; and Michael J. Sinai, PhD "Optical Coherence Tomography Angiography Imaging With Topcon' s Lamina Cribosa One-Micrometer Wavelength Swept Source Optical Coherence Tomography" Optical Coherence Tomography Angiography of the Eye (pp 71-80).
2 広角 OCT 撮影用アタッチメントレンズWA-1は別売付属品です
ダウンロード
お問い合わせフォーム
製品に関する質問から製品デモ、購入に関するお問い合わせは
下記のフォームからお問い合わせください。